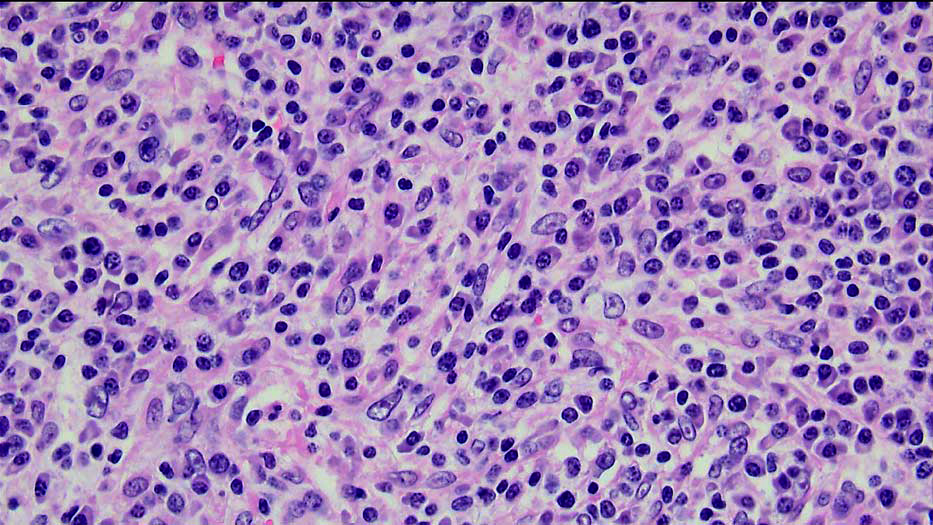

| 第 65 回 日本病理学会東北支部学術集会(JSP
−TN) 抄録データベース |
| 出題者および所属 |
|
中通総合病院 病理部1),外科2)
東海林 琢男1),田中 雄一2),小野 巌1)
|
|
| 症例の概要・問題点 |
| 症例 |
77歳 女性 |
| 既往歴 |
37歳 虫垂切除. 66歳 胆石・膵炎で入院,腹腔鏡下胆摘(胆嚢ポリープ,腺筋腫症).67歳 慢性膵炎急性増悪で入院. 69歳 膵腫瘍に対して膵中央切除,膵胃吻合術施行.病理診断:Invasive carcinoma derived from intraductal papillary adenocarcinoma(浸潤部はmucinous carcinoma).
|
| 現病歴 |
膵癌術後の経過観察中,2007年2月-3月に行われた腹部エコー,CT,およびMRIで,脾に直径約2.5cm大の腫瘍性病変が認められた.転移の可能性もあり,4月に脾摘出術が施行された.
|
4月入院時
検査所見 |
WBC 7380/μl, RBC 406×104/μl, Hb 11.6g/dl, Ht 36.4%, Plt 212000/μl,TP 7.2g/dl, Alb 4.1 g/dl, (Alb 57.9%, α1 2.9%, α2 9.8%,β 9.7%, γ 19.7%), T-bil 0.5mg/dl, AST 21IU/l, ALT 12IU/l, LDH 195IU/l, ALP 237IU/l, BUN 13.1mg/dl, Cr 0.6mg/dl, CRP 0.2 mg/dl.
|
| 肉眼所見 |
脾に,境界明瞭で,割面が黄白色均一な充実性の腫瘤(大きさ:直径約3cm)が認められた.
|
| 配布標本 |
腫瘤を含む脾組織. |
|
|
| 問題点 |
病理組織診断(組織学的に膵癌の転移ではない).
|
| 最終病理診断 |
Inflammatory pseudotumor, suspected.
|
|
|
| コメント |
紡錘形細胞のIgG4発現の検討,濾胞樹状細胞の免疫組織化学的検討の必要性についてコメントあり.形質細胞の異型は炎症性偽腫瘍で説明しうるのかとのコメントあり.また,膵炎の既往と本病変の関連の有無についての質問あり. |
|
|
|
|
|
|
|
|
|
|
|
|
|
|
|
|
|
|
|
|
画像1
|
画像2
|
 |
 |
| 肉眼所見 |
弱拡大 |
|
|
画像3
|
画像4
|
|
 |
| 強拡大 |
α-SMA免疫染色 |
|
|
|
|
|
|
|
|
|
|
|